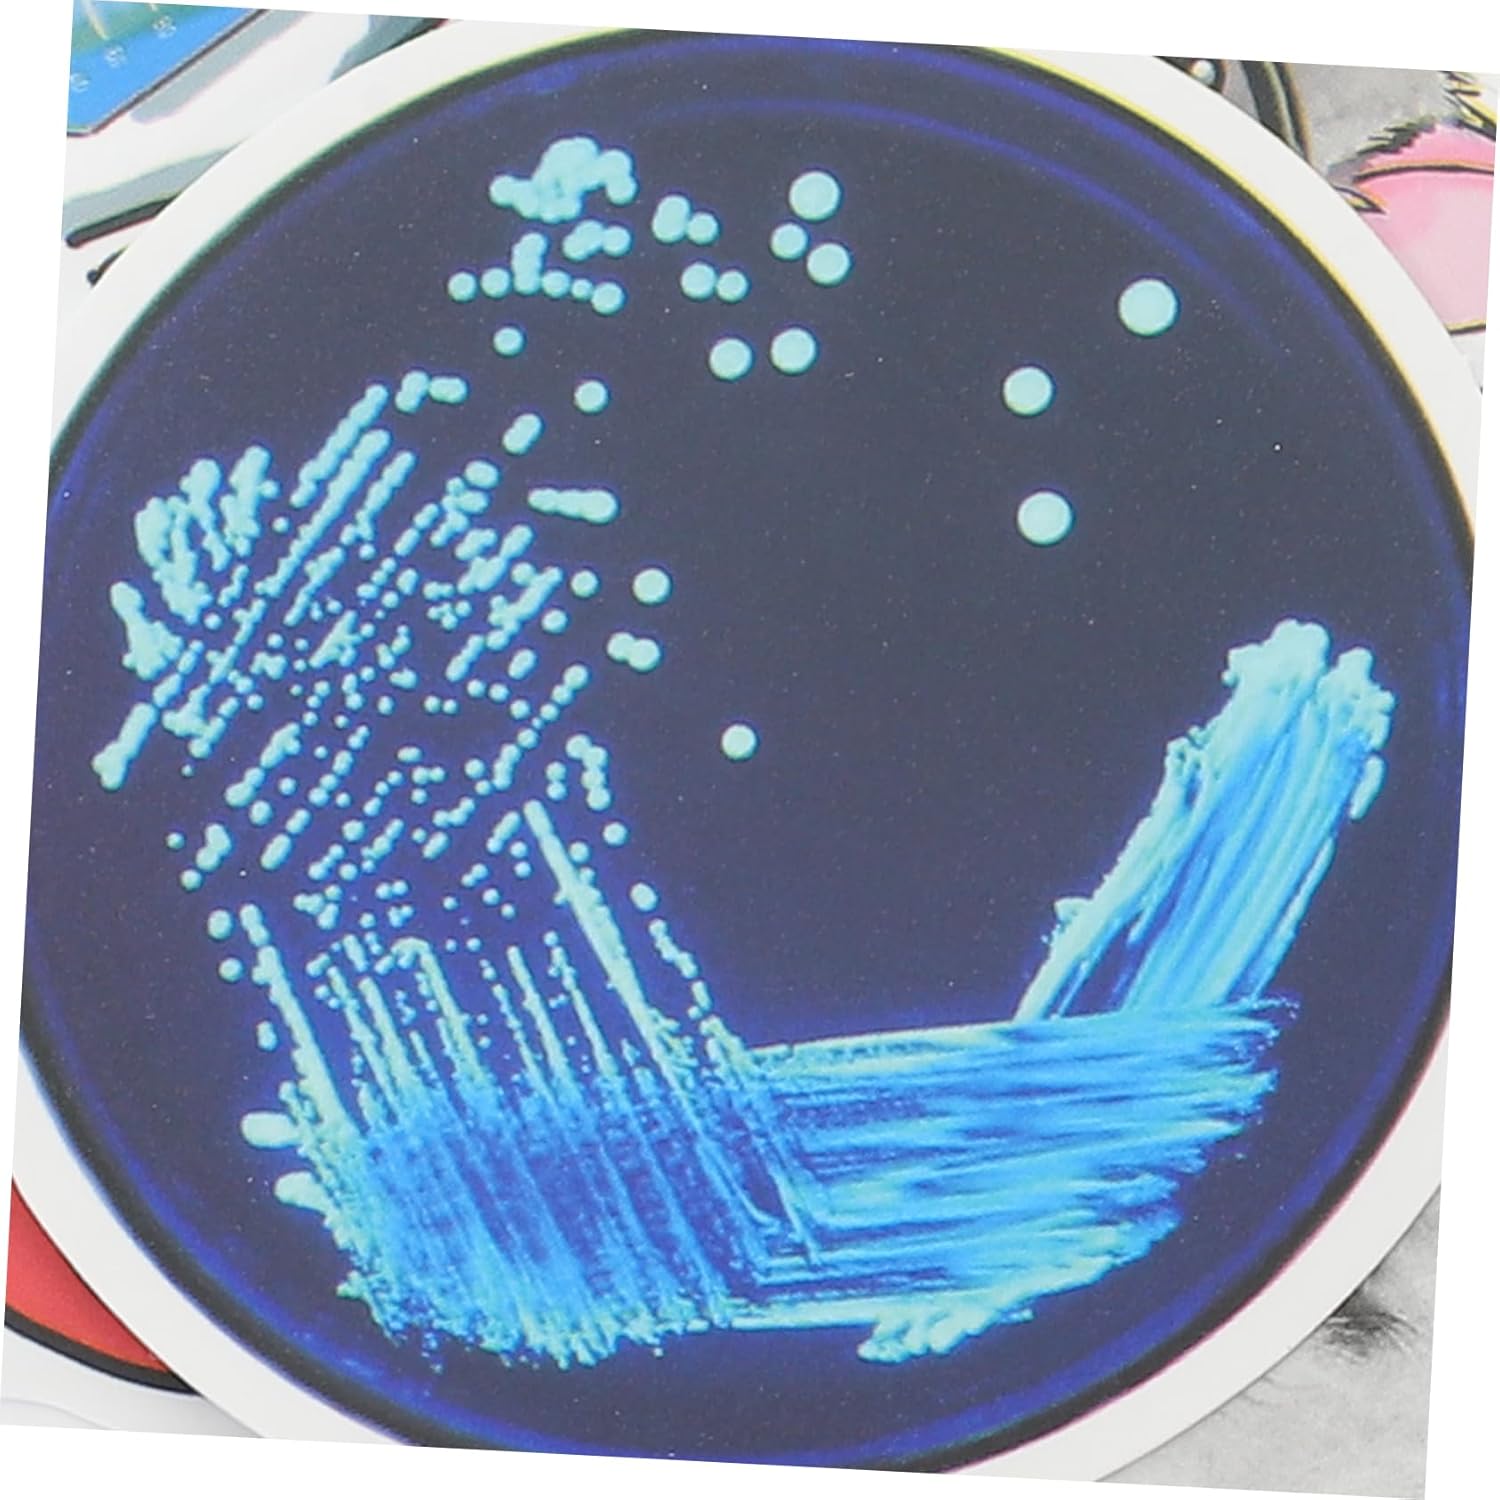

Brand:
Adesivi per valigie: gli adesivi decorativi ti aiuteranno a decorare in modo più creativo e adorabile. Adesivo per custodia da viaggio: facile da staccare senza residui e fatica, pratico e decorativo. Adesivi per bagagli: realizzati in carta e l'adesivo scientifico è sicuro da usare. Adesivi per laptop fai-da-te: adatti per laptop, computer, valigie, valigie, diari e ovunque tu voglia. Adesivi scientifici: l'adesivo scientifico è un buon materiale cartaceo, che può essere utilizzato a lungo.
| Couleur | Comme Montré |
| Dimensions du produit (L x l x h) | 6,3 x 5,5 x 0,1 cm; 41 grammes |
| Disponibilité des pièces détachées | Information indisponible sur les pièces détachées |
| Marque | HEMOTON |
| Numéro de modèle | 6Y9RFC51Y0517IDF |
| Poids de l'article | 41 g |
